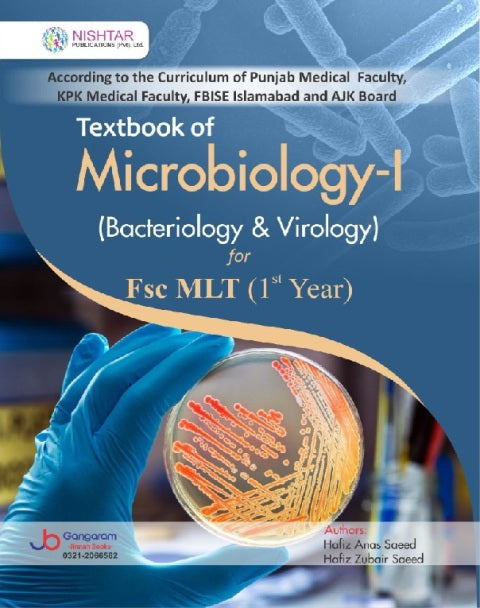
Microbiology-I Bacteriology & Virology

1
/
of
1
NOTE: Final price of products can differ from shown price.
Microbiology-I Bacteriology & Virology
Microbiology-I Bacteriology & Virology
Fsc MLT 1st Year
Author: Hafiz Anas Saeed
Publisher: Nishter Publications
Language: English
Regular price
Rs.420.00 PKR
Regular price
Rs.495.00 PKR
Sale price
Rs.420.00 PKR
Unit price
/
per
Couldn't load pickup availability
Share